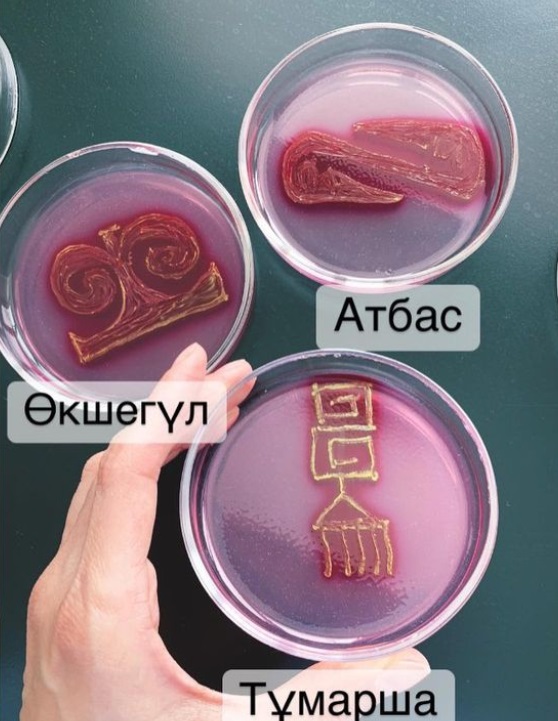

Самое читаемое
- Новый завод за $100 млн строят в Актюбинской области
- Ливни, угроза селя и тревога жителей: что происходило в Алматы последние сутки
- Самолет Air Astana не смог приземлиться в Астане и вернулся в Алматы
- Международный банк подключился к проекту реконструкции дороги Кызылорда – Саксаульск
- Под удар беспилотников попал один из крупнейших НПЗ "Лукойла"